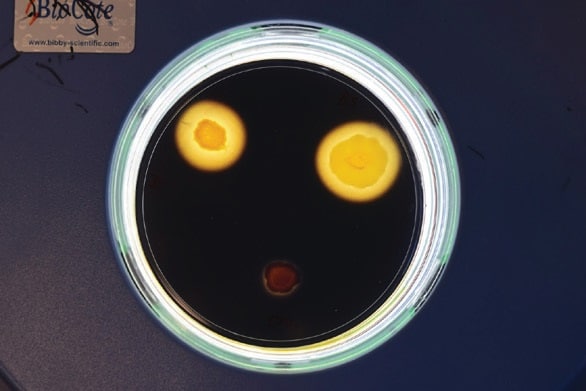
Bio Enzym - Cortec Corporation

NEWS ALERT: Cortec® VpCI® Papers: What’s Your Style?
Cortec® VpCI® Papers: What’s Your Style? February 22, 2022 Cortec® Coated Products (CCP) in Eau Claire, Wisconsin, offers a wide variety of instock VCI (Vapor Corrosion Inhibitor) papers with a fast order turnaround even in a day of supply-chain shortages. It is good to be aware of these sizing, [...]